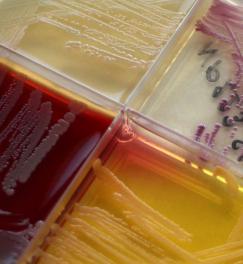

Nos concrétisations
Jeudi 14 novembre 2019 - Mis à jour le Mardi 2 janvier 2024
Découvrez les domaines d'expertise sur lesquelles travaillent les épidémiologistes et les chercheurs d'Epicentre et ce qu'ils ont déjà réalisés pour améliorer les connaissances et l'accès aux soins des populations subissant des conflits, des épidémies, des catastrophes ou pour lesquelles l’accès aux soins est insuffisant ou inexistant.
VIH/SIDA
Découvrir
Choléra
Découvrir
Tuberculose
Découvrir
Rougeole
Découvrir
Paludisme
Découvrir
Résistance antibiotique
Découvrir
Ebola
Découvrir
Maladies nutritionnelles
Découvrir
Evaluation de la santé de la population
Découvrir
Santé mentale
Découvrir
Morsures de serpent
Découvrir
Fièvre jaune
Découvrir
Complications d'avortement
Découvrir
Leishmaniose viscérale
Découvrir
Rotavirus
Découvrir
Trypanosomiase humaine africain
Découvrir
Ulcère de Buruli
Découvrir
COVID-19
Découvrir
Détresse psychologique chez les jeunes enfants
Découvrir
Hépatite E
Découvrir








